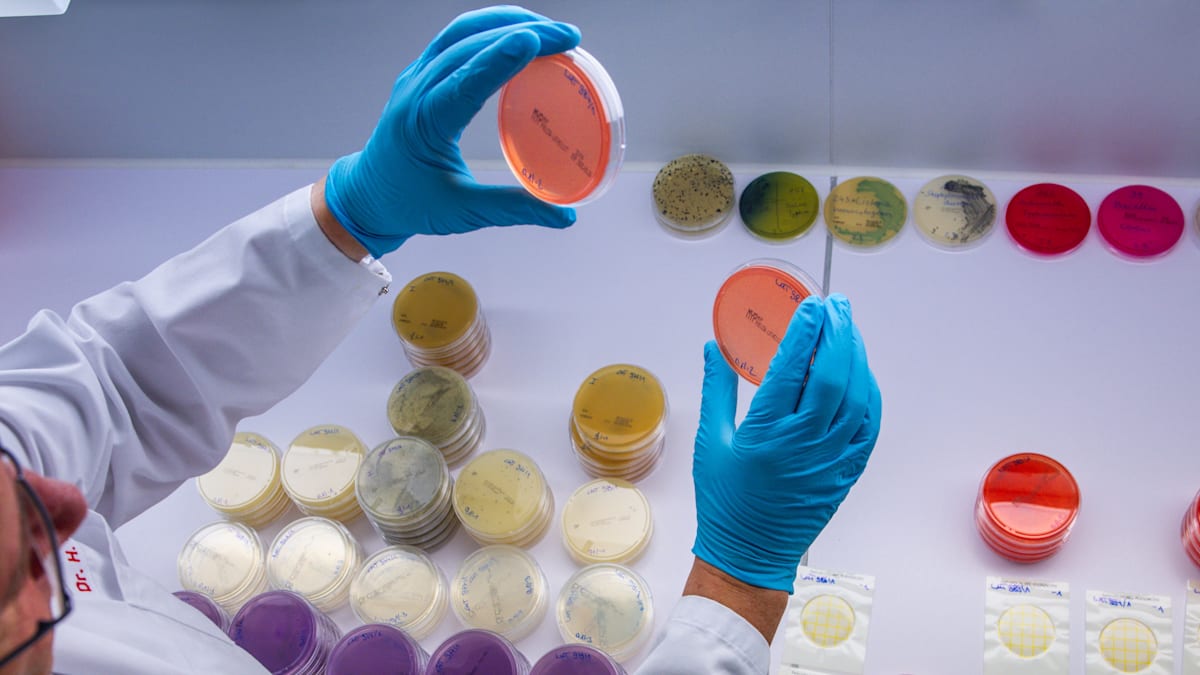
Schleswig-Holstein und Hamburg: Das Ehec-Virus breitet sich im Norden aus

Die Ehec-Infektionswelle in Mecklenburg-Vorpommern hat Schleswig-Holstein erreicht. Aktuell würden im Land 14 Fälle damit in Verbindung gebracht, sagt der Chefvirologe am Universitätsklinikum Schleswig-Holstein (UKSH) in Kiel, Helmut Fickenscher. Ein Mensch sei schwer erkrankt, sieben Patienten seien ins Krankenhaus gekommen. In Hamburg konnten bisher zwei Fälle dem Ausbruchsgeschehen zugeordnet werden, bei einem weiteren Fall steht noch eine finale Beprobung aus.
Im Nachbarland Mecklenburg-Vorpommern waren nach früheren Angaben des Landesamts für Gesundheit und Soziales (LAGuS) Anfang Oktober 126 Menschen an einer Ehec-Infektion erkrankt – darunter 65 bestätigte Fälle und 61 Verdachtsfälle. Laut Analyse des Robert Koch-Instituts (RKI) gehen auch Erkrankungen in Nordrhein-Westfalen auf den gleichen Erregerstamm zurück wie in Mecklenburg-Vorpommern.
Was ist Ehec?
Ehec steht für Enterohämorrhagische Escherichia coli – bestimmte krank machende Stämme eines Darmbakteriums, die vor allem bei Wiederkäuern vorkommen und bei Menschen insbesondere Durchfall auslösen können. Die Bakterien können auf verschiedenen Wegen übertragen werden, unter anderem durch direkten Kontakt zu Tieren oder durch den Verzehr kontaminierter Lebensmittel. In besonders schweren Verläufen kann es zum hämolytisch-urämischen Syndrom (HUS) kommen, das zu Blutgerinnungsstörungen und Nierenversagen führen kann. Vor einigen Jahren kam es dadurch im Norden zu mehreren Todesfällen.
Woran erkenne ich eine Infektion?
Sichtbare Zeichen sind ausgeprägte, oft auch blutige Durchfälle. Sie können mit Bauchschmerzen und leichtem Fieber einhergehen. Dann sollte ein Arzt konsultiert werden. Eine Besiedlung kann aber auch ohne Infektion und ohne Beschwerden verlaufen und unerkannt bleiben. Bei Durchfall ist es ratsam, wegen des Verlustes von Salz und Flüssigkeit viel zu trinken. Bei schweren Verläufen kommen Antibiotika zum Einsatz.